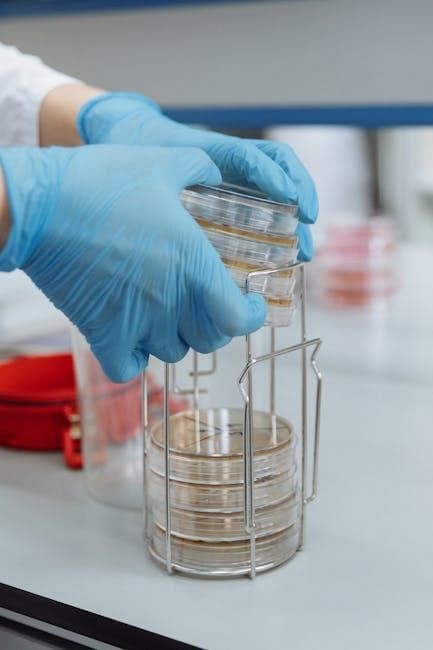

Foundations in Microbiology 12th Edition: A Comprehensive Overview
Foundations in Microbiology, 12th edition, is a detailed textbook covering core microbiology principles, including structure, genetics, and ecology, available as a PDF ebook.
Talaro’s Foundations in Microbiology, 12th Edition, represents a significant update to a cornerstone text in the field. This edition continues the tradition of providing a comprehensive and accessible introduction to the fascinating world of microorganisms. Students will benefit from detailed coverage of microbial structure, function, genetics, and ecological roles.
The 12th edition builds upon previous strengths, incorporating the latest research and advancements in microbiology. It’s available as a PDF ebook, offering convenient access to the material. Resources like the Internet Archive provide access, while platforms like VitalSource offer digital textbook options. The text aims to equip students with a solid foundation for further study and careers in microbiology and related disciplines.
Key Authors and Contributors
Foundations in Microbiology, 12th Edition, is authored by Kathleen P. Talaro and Barry Chess. These established experts bring a wealth of knowledge and experience to the text, ensuring accuracy and clarity in the presentation of complex microbiological concepts. Their collaborative effort results in a cohesive and engaging learning experience for students.
While specific details regarding additional contributors aren’t prominently featured in readily available online resources, Talaro and Chess are recognized as the primary driving forces behind this widely-used textbook. The 12th edition PDF reflects their commitment to providing a current and thorough overview of the microbial world, accessible through various platforms like VitalSource and the Internet Archive.
Core Concepts Covered in the Textbook
Talaro’s Foundations in Microbiology, 12th Edition, comprehensively explores fundamental principles. Key areas include bacterial and viral structure, detailing cellular components and replication processes. The text delves into microbial metabolism, examining energy production and utilization. A significant focus is placed on microbial genetics, covering DNA replication, gene expression, mutation, and adaptation.
Furthermore, the book investigates microbial ecology, highlighting interconnectedness within ecosystems. Applied microbiology and biotechnology, alongside microorganisms’ roles in food science, are also thoroughly addressed. The 12th edition PDF provides a robust foundation for understanding these core concepts, preparing students for advanced studies and careers in the field.
Microbial Structure and Function
Talaro’s Foundations in Microbiology, 12th edition PDF, meticulously details bacterial and viral structures, alongside their respective functions and replication mechanisms.
Bacterial Cell Structure
Talaro’s Foundations in Microbiology, 12th edition, comprehensively explores bacterial cell structure in its PDF format. This includes detailed examinations of the cell wall – its composition and variations like Gram-positive and Gram-negative types – and the crucial role of the cytoplasmic membrane.
The textbook delves into external structures such as flagella, pili, and capsules, explaining their functions in motility, attachment, and protection. Internal components like ribosomes, nucleoids, and plasmids are also thoroughly covered.

Students gain insight into endospores and their significance in bacterial survival. The PDF version provides clear illustrations and explanations, solidifying understanding of these fundamental building blocks of bacterial life.
Viral Structure and Replication
Talaro’s Foundations in Microbiology, 12th edition PDF, provides a detailed exploration of viral structure, covering the core components like the genome – DNA or RNA – and the protein coat, or capsid. It explains the diverse shapes and symmetries observed in viruses.
The textbook meticulously outlines the stages of viral replication, including attachment, penetration, uncoating, replication, assembly, and release. Lytic and lysogenic cycles are clearly differentiated, with explanations of how viruses interact with host cells.
Students benefit from visual aids and clear descriptions of viral classification and the impact of viruses on host organisms, all within the accessible PDF format.
Microbial Metabolism
Talaro’s Foundations in Microbiology, 12th edition PDF, comprehensively covers microbial metabolism, detailing how microorganisms obtain and utilize energy. It explores essential concepts like catabolism and anabolism, enzyme function, and the crucial role of ATP.
The textbook delves into various metabolic pathways, including glycolysis, the Krebs cycle, and the electron transport chain, explaining how these processes generate energy for microbial growth. It also examines alternative metabolic strategies like fermentation.
Students gain a thorough understanding of microbial nutritional requirements and the impact of environmental factors on metabolic activity, all presented within the convenient PDF format.
Microbial Genetics and Evolution

Talaro’s Foundations in Microbiology, 12th edition PDF, details DNA replication, gene expression, mutation, and microbial adaptation, offering a comprehensive genetics overview.
DNA Replication and Gene Expression

Talaro’s Foundations in Microbiology, 12th edition, comprehensively explores the intricate processes of DNA replication and gene expression within microbial systems. The PDF version meticulously details the mechanisms of DNA replication, including the roles of key enzymes and the steps involved in ensuring accurate duplication of the genetic material.
Furthermore, the text elucidates the central dogma of molecular biology, explaining how genetic information flows from DNA to RNA through transcription, and subsequently to protein through translation. It covers the regulation of gene expression, detailing how microorganisms control which genes are active at any given time, adapting to environmental changes.
Students gain a thorough understanding of these fundamental processes, crucial for comprehending microbial growth, adaptation, and evolution, all within the accessible format of the 12th edition PDF.
Mutation and Genetic Variation
Talaro’s Foundations in Microbiology, 12th edition PDF, provides a detailed examination of mutation and its role in generating genetic variation within microbial populations. The text thoroughly explains different types of mutations – point mutations, frameshift mutations, and chromosomal rearrangements – and their potential consequences on microbial phenotypes.
It further explores the mechanisms by which genetic variation arises, including mutation, horizontal gene transfer (transformation, transduction, and conjugation), and recombination. The ebook clarifies how these processes contribute to microbial evolution and adaptation, enabling microorganisms to survive in diverse and changing environments.
Students will gain a solid understanding of the significance of genetic variation in microbial diversity, antibiotic resistance, and virulence, all presented within the comprehensive 12th edition PDF.
Microbial Evolution and Adaptation
Talaro’s Foundations in Microbiology, 12th edition PDF, dedicates significant coverage to microbial evolution and adaptation, detailing how microorganisms change over time in response to environmental pressures. The text elucidates the principles of natural selection, genetic drift, and gene flow as driving forces behind microbial evolution.
It explores adaptive mechanisms employed by microbes, including the development of antibiotic resistance, metabolic versatility, and specialized survival strategies. The ebook emphasizes the rapid evolutionary rates of microorganisms and their implications for infectious disease, biotechnology, and ecological processes.
Students will learn how understanding microbial evolution is crucial for addressing global health challenges and harnessing the power of microbes for beneficial applications, all within the 12th edition PDF.

Ecology and Applied Microbiology
Talaro’s Foundations in Microbiology 12th edition PDF explores microbial ecology, biotechnology, and the role of microorganisms in food, offering a comprehensive overview.
Microbial Ecology: Interconnecting Web of Life
Talaro’s Foundations in Microbiology, 12th edition, delves into the intricate world of microbial ecology, presenting it as an “interconnecting web of life.” The textbook, available as a PDF, meticulously examines the complex relationships between microorganisms and their environments.
It explores how microbes interact with each other and with larger organisms, highlighting their crucial roles in nutrient cycling, decomposition, and maintaining ecosystem balance. The material covers diverse habitats, from soil and water to the human microbiome, emphasizing the pervasive influence of microbial communities.
Students gain insight into symbiotic relationships, microbial interactions impacting biogeochemical cycles, and the broader ecological consequences of microbial activity. This section, within the comprehensive PDF resource, provides a foundational understanding of microbial contributions to the planet’s ecosystems.
Applied Microbiology and Biotechnology
Talaro’s Foundations in Microbiology, 12th edition, extensively covers applied microbiology and biotechnology, readily accessible within the PDF version of the textbook. This section details the practical applications of microbial knowledge across diverse fields.
Students explore how microorganisms are harnessed for industrial processes, including the production of pharmaceuticals, enzymes, and biofuels. The text examines the role of microbes in bioremediation, waste treatment, and the development of sustainable technologies.
Furthermore, it delves into the applications of microbial techniques in agriculture, food science, and genetic engineering. The PDF provides a comprehensive overview of how microbial principles are translated into real-world solutions, fostering innovation and addressing global challenges.
Microorganisms and Food
Talaro’s Foundations in Microbiology, 12th edition, comprehensively explores the intricate relationship between microorganisms and food, readily available within the accessible PDF format. This section details the beneficial and detrimental roles microbes play in food production, preservation, and safety.
The textbook examines microbial contributions to fermentation processes, creating foods like yogurt, cheese, and bread. It also investigates food spoilage mechanisms and the prevention of foodborne illnesses.
Students learn about food preservation techniques, including canning, drying, and irradiation, and their impact on microbial populations. The PDF provides a detailed understanding of microbial ecology within food systems, ensuring food quality and public health.
Industrial Microbiology
Talaro’s Foundations in Microbiology, 12th edition PDF, details microbial processes utilized in various industries, covering general concepts and practical applications effectively.
General Concepts in Industrial Microbiology
Talaro’s Foundations in Microbiology, 12th edition, provides a solid grounding in the fundamental principles underpinning industrial microbiology. The PDF version comprehensively explores how microorganisms are harnessed for large-scale production of valuable products.
This includes detailed coverage of microbial growth, metabolic pathways, and genetic engineering techniques crucial for optimizing industrial processes. Students gain insight into strain selection, fermentation technology, and downstream processing.
The textbook emphasizes the importance of sterile techniques and quality control in maintaining efficient and safe industrial operations. It also touches upon the economic considerations and regulatory aspects governing the field, offering a holistic understanding of industrial microbiology’s practical applications.
Microbial Processes in Industry
Talaro’s Foundations in Microbiology, 12th edition PDF, delves into specific microbial processes utilized across diverse industries. It details how bacteria, fungi, and viruses are employed in the production of pharmaceuticals, enzymes, biofuels, and food products.
The text explores fermentation processes, bioremediation techniques, and the role of microorganisms in waste treatment. Students learn about the production of antibiotics, vitamins, and amino acids through microbial synthesis.
Furthermore, the book examines the application of microbial processes in the development of sustainable technologies, emphasizing the potential of biotechnology to address environmental challenges and improve industrial efficiency. It provides a practical understanding of how microbiology drives innovation in various sectors.

Textbook Appendices and Resources
Foundations in Microbiology, 12th edition PDF, includes helpful appendices covering exponents, significant microbiology events, sterilization methods, and a glossary of terms.
Appendix A: Exponents
Appendix A within Talaro’s Foundations in Microbiology, 12th edition, provides a concise review of exponents, a fundamental mathematical concept crucial for understanding microbial growth calculations. This section serves as a refresher for students needing to quickly recall the rules governing exponential notation.
It details how to manipulate exponential expressions, covering operations like multiplication, division, and raising powers to powers. The appendix is designed to ensure students possess the necessary mathematical foundation to interpret data presented throughout the textbook, particularly in chapters discussing bacterial populations and logarithmic scales.
Understanding exponents is vital for comprehending concepts like generation time and the impact of growth rates on microbial cultures. This resource aids in solidifying these essential mathematical skills.
Appendix B: Significant Events in Microbiology
Appendix B of Talaro’s Foundations in Microbiology, 12th edition, presents a chronological timeline of pivotal discoveries and advancements in the field of microbiology. This historical overview highlights key milestones, from the initial observations of microorganisms using early microscopes to the development of modern immunological techniques.

The appendix details breakthroughs like Pasteur’s disproof of spontaneous generation, Koch’s postulates establishing links between microbes and disease, and the discovery of viruses and antibiotics. It contextualizes the evolution of microbiological knowledge, demonstrating how each discovery built upon previous work.
This resource provides students with a broader understanding of the scientific journey that shaped our current understanding of the microbial world.
Appendix C: Sterilization and Germicidal Processes
Appendix C within Talaro’s Foundations in Microbiology, 12th edition, comprehensively details methods for eliminating or reducing microbial populations. It explores various sterilization techniques, including physical methods like heat (autoclaving, pasteurization) and filtration, alongside chemical sterilization using disinfectants and antiseptics.
The appendix clarifies the differences between sterilization, disinfection, and antisepsis, emphasizing the importance of appropriate methods for different applications. It provides detailed information on germicidal processes, outlining the mechanisms of action and effectiveness of various chemical agents against different microbial types.
This resource is crucial for understanding microbial control in healthcare, industry, and everyday life.
Appendix D: Classification of Microbial Disease Agents
Appendix D in Talaro’s Foundations in Microbiology, 12th edition, presents a systematic classification of major microbial disease agents. This appendix organizes pathogens based on several key criteria, including the affected body system (e.g., respiratory, nervous, digestive), the primary site of infection, and the routes of transmission.
It categorizes agents by type – bacteria, viruses, fungi, and parasites – providing a concise overview of diseases caused by each. This classification aids in understanding disease pathology and epidemiology.
The appendix serves as a valuable reference for quickly identifying agents associated with specific illnesses and their modes of spread.
Appendix E: Answers to Questions and Glossary
Appendix E of Talaro’s Foundations in Microbiology, 12th edition, provides essential support for student learning. It contains detailed answers to multiple-choice and matching questions presented throughout the textbook, allowing for self-assessment and reinforcement of key concepts.
Crucially, this appendix also includes a comprehensive glossary of microbiology terms. This glossary defines specialized vocabulary, aiding comprehension of complex topics.
Both components – answers and glossary – are invaluable resources for students studying the material and preparing for examinations, ensuring a firm grasp of the subject matter.

Availability and Access Options
Foundations in Microbiology, 12th edition, is accessible as a PDF ebook for download or purchase, and also via digital access through VitalSource platforms.
PDF Download and Purchase Information
Foundations in Microbiology, 12th edition, in PDF format, is readily available through various online platforms. Studentebookhub.com offers the ebook for purchase, providing a preview of the first 55 pages.
Upon successful payment, a download button appears, and a download link is also emailed to the user. The Internet Archive also lists the book, detailing its contents including appendices and glossaries.
Potential buyers should be aware of legitimate sources to ensure they receive a quality, complete copy of this comprehensive microbiology textbook. Always verify the source before completing a purchase to avoid potential issues.
Digital Textbook Access via VitalSource
Talaro’s Foundations in Microbiology, 12th Edition, is conveniently accessible digitally through VitalSource. This platform provides an eTextbook version authored by Barry Chess and published by McGraw-Hill Higher Education.
VitalSource offers a flexible learning experience, allowing students to access the textbook on various devices. The ISBNs for the digital and eTextbook versions are 9781265739362 and 9781265631840, respectively.
Choosing VitalSource provides a cost-effective and environmentally friendly alternative to a physical copy, offering features like search, highlighting, and note-taking capabilities for enhanced studying.